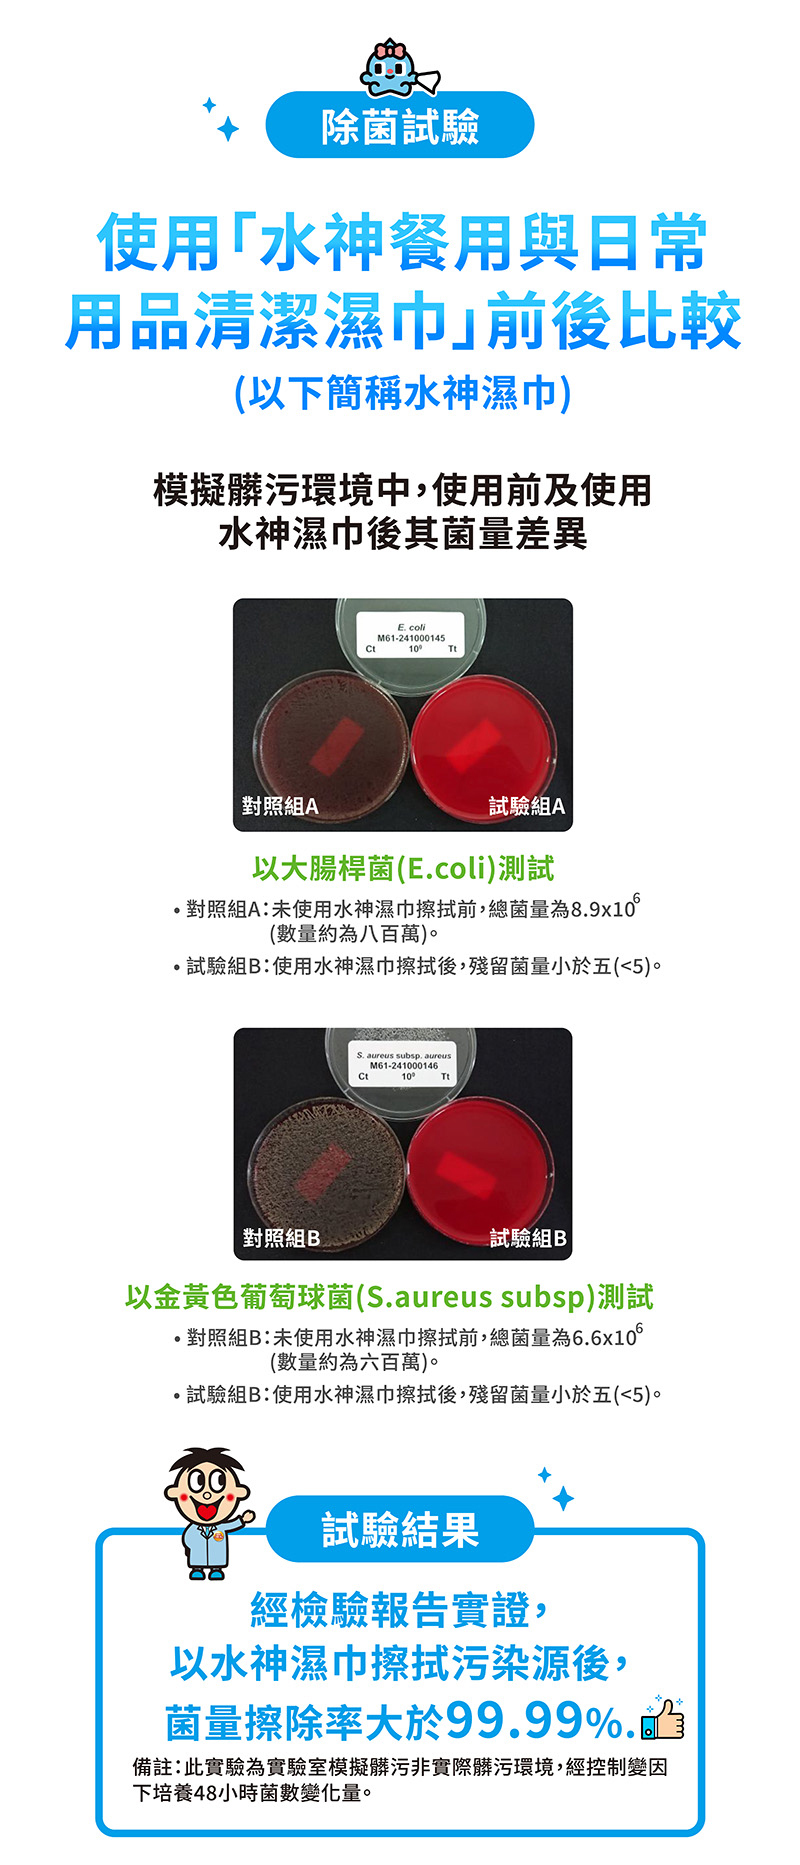

{{ 'fb_in_app_browser_popup.desc' | translate }} {{ 'fb_in_app_browser_popup.copy_link' | translate }}
{{ 'in_app_browser_popup.desc' | translate }}
{{ childProduct.title_translations | translateModel }}
{{ getChildVariationShorthand(childProduct.child_variation) }}
{{ getSelectedItemDetail(selectedChildProduct, item).childProductName }} x {{ selectedChildProduct.quantity || 1 }}
{{ getSelectedItemDetail(selectedChildProduct, item).childVariationName }}
經第三方檢驗單位實證,可擦去99.9%的細菌,如:大腸桿菌與金黃色葡萄球菌…等。
★無酒精,溫和不乾澀,不傷手部肌膚,不損壞用品。
★無螢光增白劑、無香料,不引起過敏。
★紙質厚實細緻、不易破,保濕性佳。
★不連張,抽取使用方便。
商品存貨不足,未能加入購物車
您所填寫的商品數量超過庫存
{{'products.quick_cart.out_of_number_hint'| translate}}
{{'product.preorder_limit.hint'| translate}}
每筆訂單限購 {{ product.max_order_quantity }} 件
現庫存只剩下 {{ quantityOfStock }} 件

產品介紹
經第三方檢驗單位實證,可擦去99.9%的細菌,如:大腸桿菌與金黃色葡萄球菌…等。
特色:
A. 無酒精,溫和不乾澀,不傷手部肌膚,不損壞用品。
B. 無螢光增白劑、無香料,不引起過敏。
C. 紙質厚實細緻、不易破,保濕性佳。
D. 不連張,抽取使用方便。
適用範圍與建議:
A. 餐具清潔:碗盤、刀叉筷、水杯…等
B. 餐桌清潔
C. 兒童玩具與周邊用品清潔
D. 電腦螢幕與鍵盤清潔
E. 汽車方向盤清潔
F. 家電遙控器清潔
G. 馬桶坐墊清潔